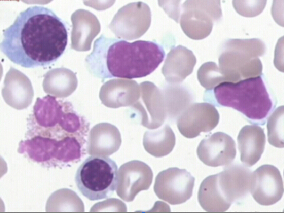
慢性淋巴细胞性白血病:hOCT1是合适的苯达莫司汀转运体

-
儿童ALL患者ABCB1突变影响疾病复发率、骨髓毒性和肝…
环球医学资讯
 2015年08月18日
2015年08月18日 点击量:638
点击量:638 1小时条评论
1小时条评论儿童急性淋巴细胞白血病(ALL)是最常见的儿童肿瘤性疾病。2015年8月,发表在《Pharmacogenomics J.》的一项研究旨在评估ABCB1突变与儿童ALL结局与毒性间关联。结果表明,儿童ALL患者ABCB1突变影响复发率、骨髓毒性和肝毒性。 膜转运体P-糖蛋白,由ABCB1基因编码,...
-
MRP4多态性影响儿童ALL维持治疗期间6-MP和MTX剂量
环球医学资讯
 2015年08月18日
2015年08月18日 点击量:405
点击量:405 1小时条评论
1小时条评论多药耐药蛋白4(MRP4)参与核苷衍生物外排,并在药物敏感性测定中起重要作用。2015年8月,发表在《Pharmacogenomics J.》的一篇文章表明,MRP4基因分型有可能对日本ALL儿童维持治疗期间6-MP个体化治疗剂量有益。 多药耐药蛋白4(MRP4)参与核苷衍生物外排,并在药物...
-
苯达莫司汀、沙利度胺和地塞米松联合治疗复发/难治…
环球医学资讯
 2015年08月18日
2015年08月18日 点击量:688
点击量:688 1小时条评论
1小时条评论骨髓瘤是一种起源于骨髓中浆细胞的常见恶性肿瘤。有单发性和多发性之分,以后者多见。2015年8月发表在《Br J Haematol.》的一项英国研究,探究了苯达莫司汀、沙利度胺和地塞米松联合治疗复发/难治骨髓瘤的有效性与安全性。 nbsp; 对硼替佐米和来那度胺耐药的复发骨...
-
慢性淋巴细胞性白血病:hOCT1是合适的苯达莫司汀转…
环球医学资讯
 2015年08月18日
2015年08月18日 点击量:349
点击量:349 1小时条评论
1小时条评论苯达莫司汀可单独或与其它抗肿瘤药物联合治疗慢性淋巴细胞白血病(CLL)、乳腺癌等恶性肿瘤。2015年8月发表在《Pharmacogenomics J.》的一项由西班牙和德国科学家进行的研究表明,在慢性淋巴细胞性白血病的治疗中,hOCT1是合适的苯达莫司汀转运体。 nbsp; 苯达莫司...
-
慢性ITP新的联合疗法显示出前景
环球医学资讯
 2015年08月17日
2015年08月17日 点击量:250
点击量:250 1小时条评论
1小时条评论有报告显示,免疫抑制联合高剂量地塞米松和利妥昔单抗用于原发性免疫血小板减少症(ITP)显示出治疗前景。2015年7月,发表在《Blood》的一项研究显示,该新的联合治疗的6个月的治疗有效率为60%且治疗耐受性良好。应答者12和24个月的无复发生存率分别为92%和76%。 ...
-
血液肿瘤和实体肿瘤专家对临终关怀的不同态度
环球医学资讯
 2015年08月14日
2015年08月14日 点击量:452
点击量:452 1小时条评论
1小时条评论生命末期的肿瘤患者是应该进行积极治疗还是姑息治疗?2015年7月,发表在《Ann Oncol.》的一项研究调查了血液肿瘤和实体肿瘤专家对临终关怀的不同态度。结果表明,血液肿瘤专家和实体肿瘤专家在临终关怀态度及信念方面存在显著差异。 背景:血液肿瘤患者在生命终期通...
-
既往化疗后进展的非小细胞肺癌:厄洛替尼vs吉非替尼
环球医学资讯
 2015年08月14日
2015年08月14日 点击量:375
点击量:375 1小时条评论
1小时条评论肺癌是英国第二大癌症杀手。超过70%的肺癌是非小细胞肺癌(NSCLCs)。2015年6月,发表在《Health Technol Assess.》一项研究在先前化疗后出现疾病进展的NSCLCs患者中,评价厄洛替尼和吉非替尼的临床疗效和成本效果,并与多西他赛或最佳支持性护理(BSC)进行比较。 ...
-
基于剩余寿命风险的乳腺癌预防指南存在的问题
环球医学资讯
 2015年08月14日
2015年08月14日 点击量:379
点击量:379 1小时条评论
1小时条评论乳腺癌的预防已成为目前广大女性关注的焦点。在美国,RLR(剩余寿命风险)为20%或更高的妇女符合MRI筛查的高危标准。2015年5月,发表在《J Natl Cancer Inst》的一项研究通过IBIS和BOADICA模型,比较RLRs及10年风险的准确性。结果表明,对于高危女性,基于RLR的指南...
-
mCRC患者:贝伐珠单抗二线治疗的最佳使用剂量
环球医学资讯
 2015年08月14日
2015年08月14日 点击量:301
点击量:301 1小时条评论
1小时条评论靶向药物联合化疗是转移性结直肠癌(mCRC)患者的标准治疗方法。2015年7月,发表在《Ann Oncol.》的一项III期研究在贝伐珠单抗+以奥沙利铂为基础的一线治疗后,比较两种剂量的贝伐珠单抗(5或10 mg/kg)联合伊立替康,5-氟尿嘧啶/亚叶酸(FOLFIRI)的二线治疗的结果...
-
局部晚期前列腺癌:ADT联合放疗优于单独使用ADT吗?
环球医学资讯
 2015年08月14日
2015年08月14日 点击量:381
点击量:381 1小时条评论
1小时条评论2015年7月,发表于《J Clin Oncol》的一篇文章介绍了局部晚期前列腺癌患者使用雄性激素阻断疗法联合放射治疗vs单独使用雄性激素阻断治疗的组内随机研究的最终报告。 nbsp; 目的:我们曾报道在雄激素阻断(ADT)疗法基础上添加放疗(RT)会改善局部晚期前列腺癌男性...

会员登录
会员登录

